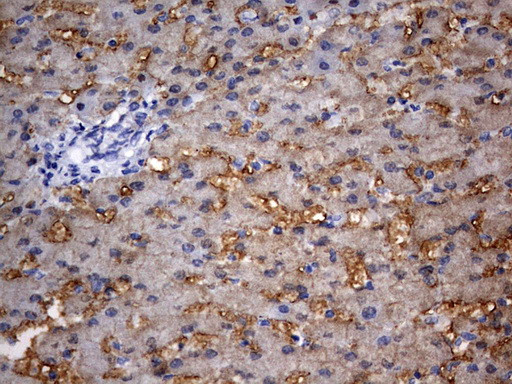
RIPK3 Antibody in Immunohistochemistry (Paraffin) (IHC (P))

Search
OriGene
RIPK3 Monoclonal Antibody (OTI3A3), TrueMAB™
{{$productOrderCtrl.translations['antibody.pdp.commerceCard.promotion.promotions']}}
{{$productOrderCtrl.translations['antibody.pdp.commerceCard.promotion.viewpromo']}}
{{$productOrderCtrl.translations['antibody.pdp.commerceCard.promotion.promocode']}}: {{promo.promoCode}} {{promo.promoTitle}} {{promo.promoDescription}}. {{$productOrderCtrl.translations['antibody.pdp.commerceCard.promotion.learnmore']}}
产品信息
CF803231
种属反应
宿主/亚型
分类
类型
克隆号
抗原
偶联物
形式
浓度
纯化类型
保存液
内含物
保存条件
运输条件
产品详细信息
For reconstitution, we recommend adding 100 µL distilled water to a final antibody concentration of about 1 mg/mL. To use this carrier-free antibody for conjugation experiments, we strongly recommend performing another round of desalting. (Zeba Spin Desalting Columns, 7KMWCO, 0.5 mL, Product # 89882)
靶标信息
RIPK3 is a member of the receptor-interacting protein (RIP) family of serine/threonine protein kinases, which contains a C-terminal domain unique from other RIP family members. RIPK3 is predominantly localized to the cytoplasm, and specifically, are colocalized in the mitochondrion which can undergo nucleocytoplasmic shuttling dependent on novel nuclear localization and export signals. RIPK3 is a component of the tumor necrosis factor (TNF) receptor-I signaling complex, and can induce apoptosis and weakly activate the NF-kappaB transcription factor and caspase-8 prevents RIPK3-dependent necrosis without inducing apoptosis by functioning in a proteolytically active complex with CFLAR and that this complex is required for the protective function.
仅用于科研。不用于诊断过程。未经明确授权不得转售。
篇参考文献 (0)
生物信息学
蛋白别名: receptor interacting protein 3; Receptor-interacting protein 3; receptor-interacting serine-threonine kinase 3; Receptor-interacting serine/threonine-protein kinase 3; RIP-3; RIP-like protein kinase 3
基因别名: RIP3; RIPK3
UniProt ID: (Human) Q9Y572
Entrez Gene ID: (Human) 11035